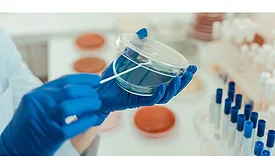

Buyers Guide
Are you sure you want to leave before submitting your RFP?

Search our Buyer’s Guide to find suppliers, manufacturers, and distributors of adhesive and sealant equipment for formulation and production.
LANXESS Corp.
Company Profile
LANXESS Corp.
111 RIDC Park W. Dr.
Pittsburgh,
PA
15275
United States
Phone: (412) 809-1000
(360) 954-7100
LANXESS is a leading specialty chemicals company with sales of EUR 6.4 billion in 2024. The company currently has about 12,000 employees in 32 countries. The core business of LANXESS is the development, manufacturing and marketing of chemical intermediates, additives and consumer protection products. LANXESS has achieved leading positions in the Dow Jones Best-in-Class Index and the MSCI ESG and ISS ESG ratings, among others, for its commitment to sustainability.
Product Categories
Articles
A Biocide for Many Seasons
An EPA-registered sodium benzoate is approved in the U.S. for use as an in-can biocide in waterborne adhesives, coatings, inks, homecare products, raw materials, and other applications.
April 7, 2022
LANXESS to Present Expanded Portfolio for Adhesives and Sealants at ASC Convention & EXPO
The company will feature plasticizers, modifiers, urethane systems, and biocides at booth 308.
October 25, 2021
LANXESS to Acquire Emerald Kalama Chemical
The sale will include all of Emerald's operations in Washington state, the UK, and the Netherlands.
February 22, 2021
Advancing Adhesives
Modifying Expectations: Novel Urethane Modifiers Outperform Traditional Plasticizers
New urethane-grade modifiers are demonstrating significant potential for formulators to improve performance in polyurethane adhesives and sealants.
November 6, 2020
Emerald Kalama Chemical Completes FIFRA Registration for Sodium Benzoate Product
Emerald Kalama Chemical reports that FIFRA registration makes its Kalaguard SB sodium benzoate available for use in North America for in-container control of bacteria, yeasts, and molds in industrial and household products.
November 2, 2020
Emerald Kalama Chemical Names Herbst Vice President and General Manager of Consumer Specialties
In this role, Wendy Herbst will be responsible for the strategic direction and all commercial and operational aspects of the global business.
April 10, 2020
Pippine Promoted to Vice President of Marketing and Technology for Emerald Kalama Chemical
Kelly Pippine has more than 20 years of marketing, commercial, and technical experience in specialty materials.
April 3, 2020
Emerald Kalama Chemical Opens New European Central Office in Rotterdam
The new office will house Emerald’s growing team for order fulfillment and technical service, focused on serving customers worldwide for products manufactured at Emerald’s operations in Europe.
October 31, 2019
Keep the info flowing with our newsletters!
Get the latest industry updates tailored your way.
JOIN TODAY!Copyright ©2026. All Rights Reserved BNP Media, Inc. and BNP Media II, LLC.
Design, CMS, Hosting & Web Development :: ePublishing
.webp?height=168&t=1704834340&width=275)